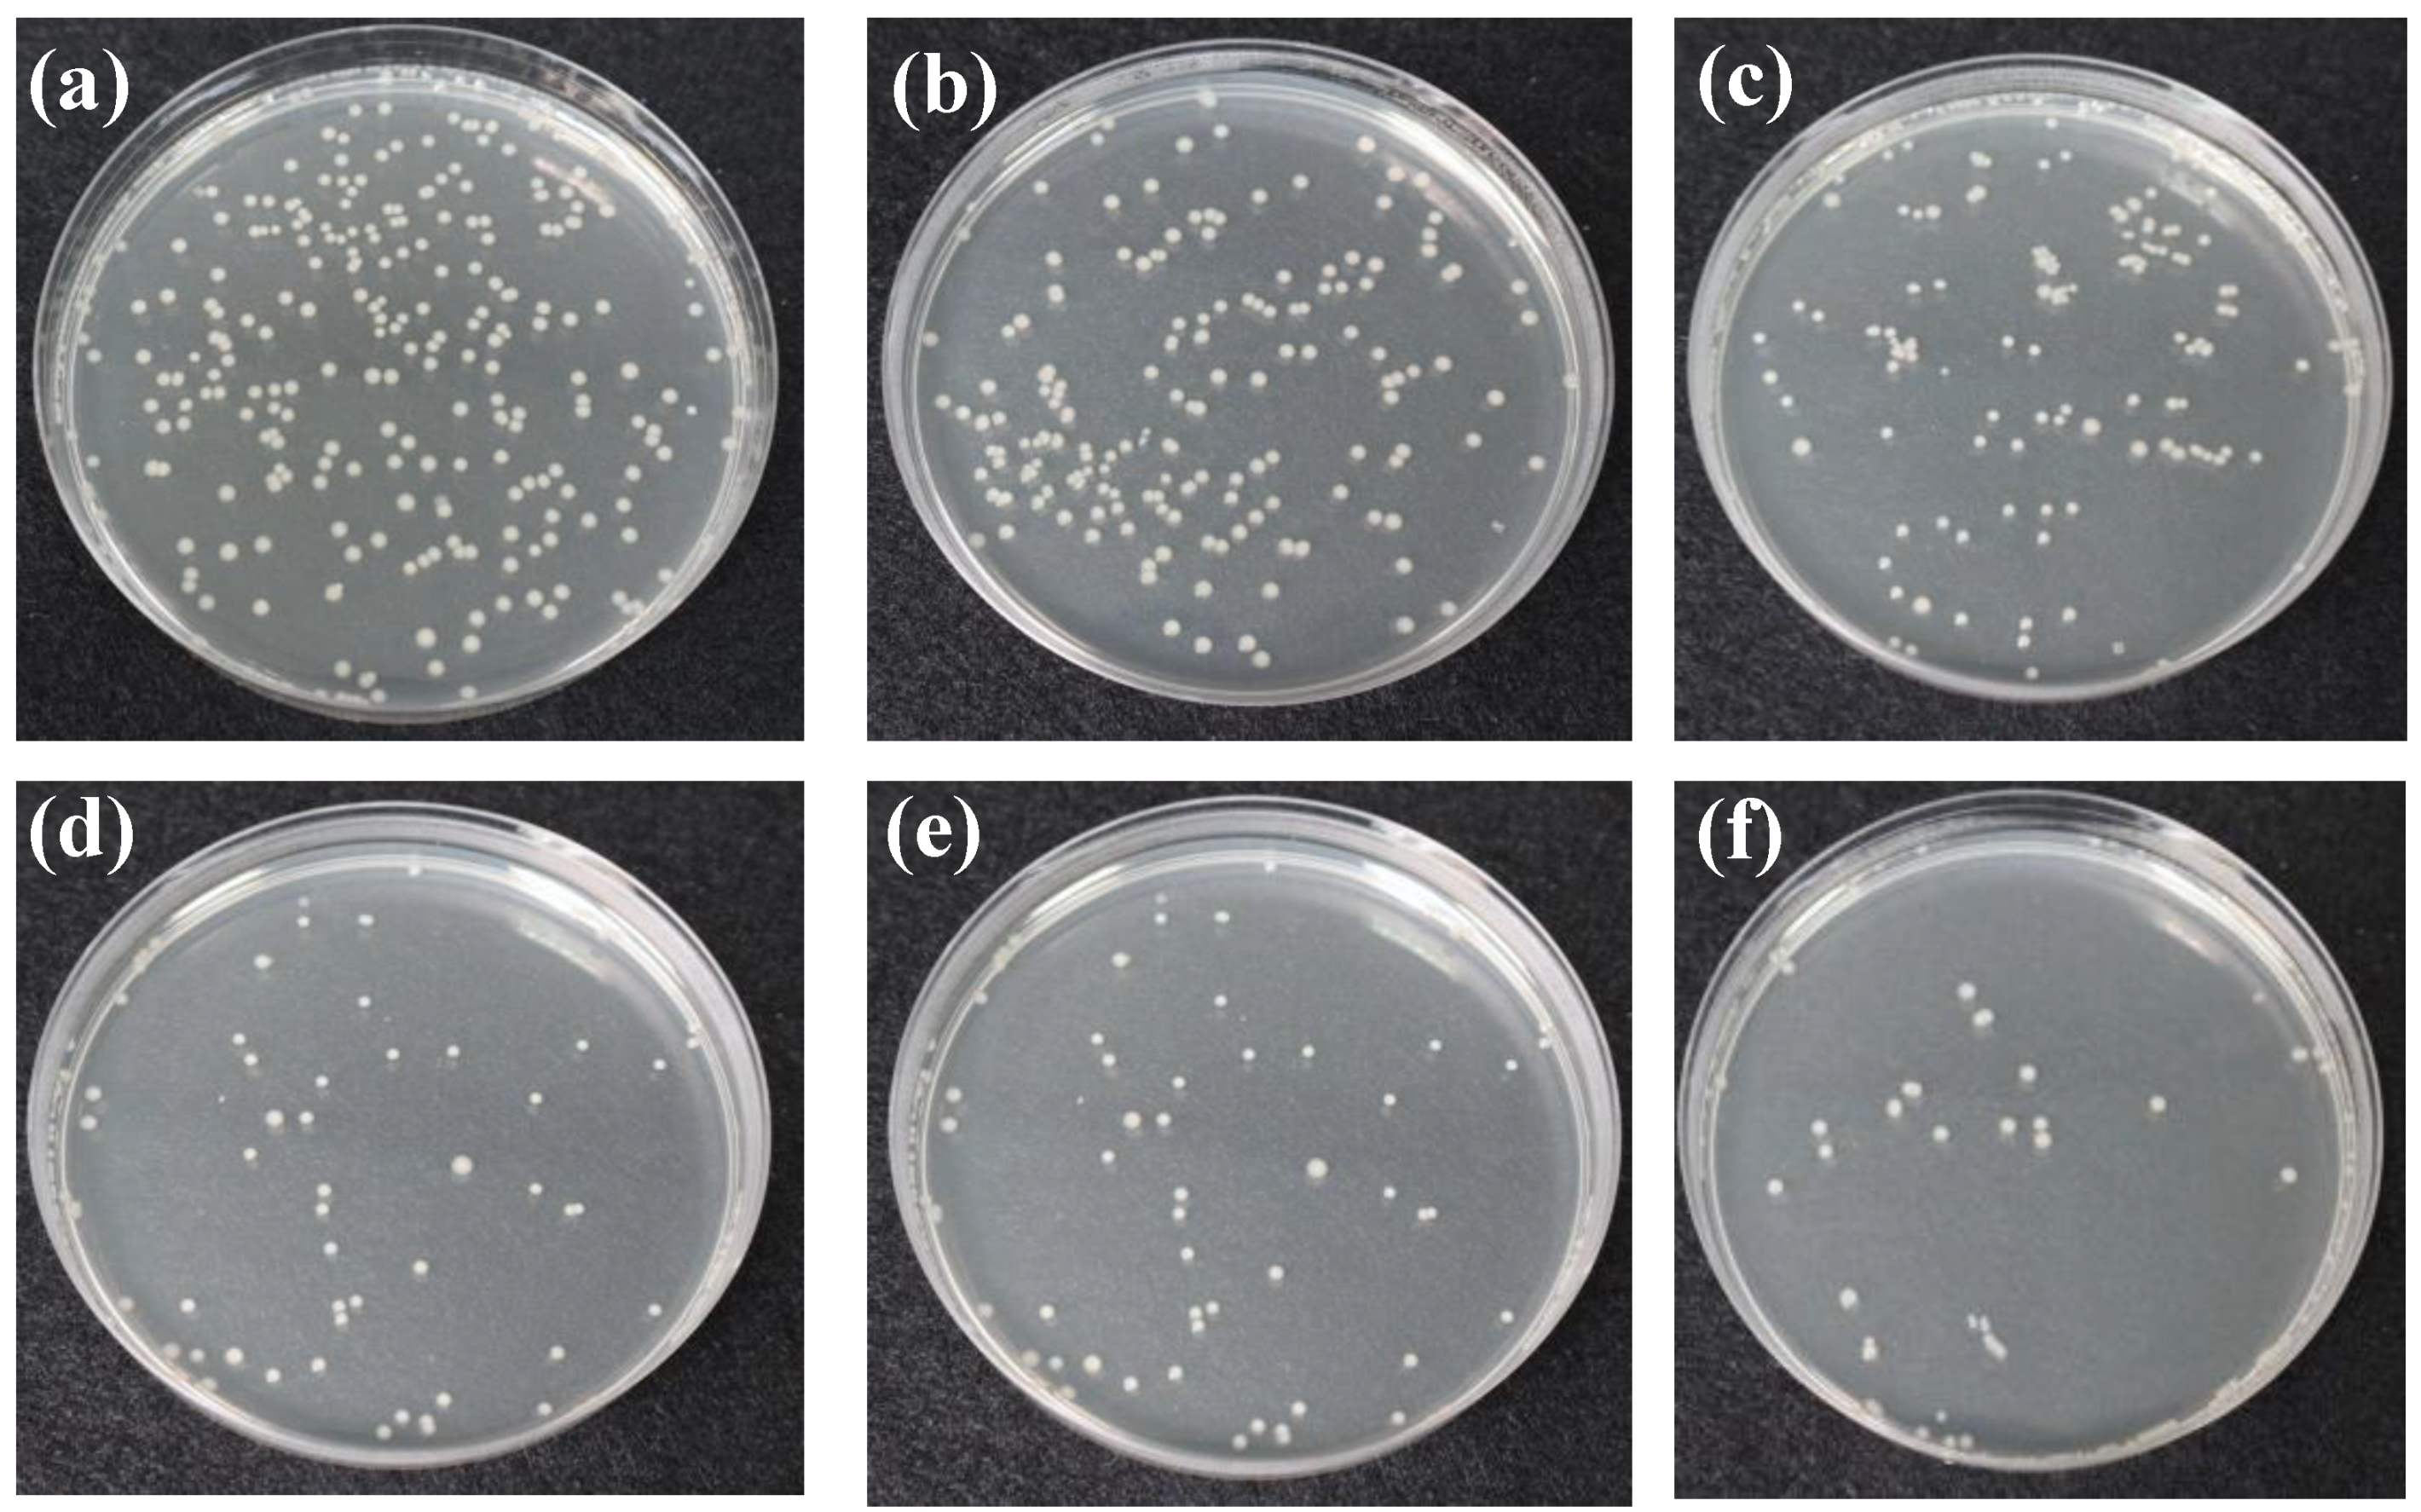
Applsci 11 05021 g008

Functional Antibacterial Nanometer Zinc Ion Yarns: Manufacturing Technique and Antimicrobial Efficacy against Escherichia coli
Abstract
:1. Introduction
2. Materials and Methods
2.1. Materials
2.2. Preparation for Microcapsules
2.3. Measurements
2.3.1. Mechanical Properties of Twisted Yarns
2.3.2. Mechanical Properties of Knitted Fabrics
2.3.3. Water Vapor Transmission Rate (WVTR) of Knitted Fabrics
2.3.4. Air Permeability of Knitted Fabrics
2.3.5. Ultraviolet/Visible Spectrophotometer (UV-Vis) Antibacterial Efficacy (OD600) of Knitted Fabrics
2.3.6. Washing Test
2.3.7. Antimicrobial Assay of Knitted Fabrics
2.3.8. Statistical Analysis
3. Results and Discussion
3.1. Surface Observation of Functional Antibacterial Yarns Based on the Twist Coefficient
3.2. Effects of Twist Coefficient on Water Vapor Transmission Rate (WVTR) of Functional Antibacterial Knitted Fabrics
3.3. Effects of Twist Coefficient on Air Permeability of Functional Antibacterial Knitted Fabrics
3.4. Effects of Twist Coefficient on Antimicrobial Efficacy of Functional Antibacterial Knitted Fabrics Based on UV-Vis Analysis
3.5. Effects of Twist Coefficient on Antibacterial Rate of Functional Antibacterial Knitted Fabrics
4. Conclusions
Author Contributions
Funding
Institutional Review Board Statement
Informed Consent Statement
Data Availability Statement
Conflicts of Interest
References
- Perera, S.; Bhushan, B.; Bandara, R.; Rajapakse, G.; Rajapakse, S.; Bandara, C. Morphological, antimicrobial, durability, and physical properties of untreated and treated textiles using silver-nanoparticles. Colloids Surf. A Phys. Eng. Asp. 2013, 436, 975–989. [Google Scholar] [CrossRef]
- Wang, L.; He, D.; Qian, L.; He, B.; Li, J. Preparation of conductive cellulose fabrics with durable antibacterial properties and their application in wearable electrodes. Int. J. Biol. Macromol. 2021. [Google Scholar] [CrossRef]
- Li, T.-T.; Pan, Y.-J.; Hsieh, C.-T.; Lou, C.-W.; Chuang, Y.-c.; Huang, Y.-T.; Lin, J.-H. Comfort and functional properties of far-infrared/anion-releasing warp-knitted elastic composite fabrics using bamboo charcoal, copper, and phase change materials. Appl. Sci. 2016, 6, 62. [Google Scholar] [CrossRef] [Green Version]
- Zain, N.M.; Stapley, A.; Shama, G. Green synthesis of silver and copper nanoparticles using ascorbic acid and chitosan for antimicrobial applications. Carbohydr. Polym. 2014, 112, 195–202. [Google Scholar] [CrossRef] [Green Version]
- Colclasure, V.J.; Soderquist, T.J.; Lynch, T.; Schubert, N.; McCormick, D.S.; Urrutia, E.; Knickerbocker, C.; McCord, D.; Kavouras, J.H. Coliform bacteria, fabrics, and the environment. Am. J. Infect. Control 2015, 43, 154–158. [Google Scholar] [CrossRef]
- Owen, L.; Laird, K. The role of textiles as fomites in the healthcare environment: A review of the infection control risk. PeerJ 2020, 8, e9790. [Google Scholar] [CrossRef]
- Gandotra, R.; Chen, Y.-R.; Murugesan, T.; Chang, T.-W.; Chang, H.-Y.; Lin, H.-N. Highly efficient and morphology dependent antibacterial activities of photocatalytic cuxo/zno nanocomposites. J. Alloy. Compd. 2021, 873, 159769. [Google Scholar] [CrossRef]
- Arunachalam, A.; Dhanapandian, S.; Manoharan, C.; Sivakumar, G. Physical properties of zn doped tio2 thin films with spray pyrolysis technique and its effects in antibacterial activity. Spectrochim. Acta Part A Mol. Biomol. Spectrosc. 2015, 138, 105–112. [Google Scholar] [CrossRef] [PubMed]
- Mao, H.; Zhang, B.; Nie, Y.; Tang, X.; Yang, S.; Zhou, S. Enhanced antibacterial activity of v-doped zno@ sio2 composites. Appl. Surf. Sci. 2021, 546, 149127. [Google Scholar] [CrossRef]
- Shi, L.; Zhou, J.; Gunasekaran, S. Low temperature fabrication of zno–whey protein isolate nanocomposite. Mater. Lett. 2008, 62, 4383–4385. [Google Scholar] [CrossRef]
- Espitia, P.J.P.; Soares, N.d.F.F.; dos Reis Coimbra, J.S.; de Andrade, N.J.; Cruz, R.S.; Medeiros, E.A.A. Zinc oxide nanoparticles: Synthesis, antimicrobial activity and food packaging applications. Food Bioprocess Technol. 2012, 5, 1447–1464. [Google Scholar] [CrossRef]
- Catauro, M.; Barrino, F.; Dal Poggetto, G.; Milazzo, M.; Blanco, I.; Ciprioti, S.V. Structure, drug absorption, bioactive and antibacterial properties of sol-gel sio2/zro2 materials. Ceram. Int. 2020, 46, 29459–29465. [Google Scholar] [CrossRef]
- Catauro, M.; Tranquillo, E.; Poggetto, G.D.; Naviglio, S.; Barrino, F. Antibacterial Properties of Sol–Gel Biomaterials with Different Percentages of PEG or PCL. Macromol. Symp. 2020, 389, 1900056. [Google Scholar] [CrossRef]
- Sricharussin, W.; Threepopnatkul, P.; Neamjan, N. Effect of various shapes of zinc oxide nanoparticles on cotton fabric for uv-blocking and anti-bacterial properties. Fibers Polym. 2011, 12, 1037–1041. [Google Scholar] [CrossRef]
- Xie, Y.; Wang, Y.; Zhang, T.; Ren, G.; Yang, Z. Effects of nanoparticle zinc oxide on spatial cognition and synaptic plasticity in mice with depressive-like behaviors. J. Biomed. Sci. 2012, 19, 1–11. [Google Scholar] [CrossRef] [PubMed] [Green Version]
- Esparza-González, S.; Sánchez-Valdés, S.; Ramírez-Barrón, S.; Loera-Arias, M.; Bernal, J.; Melendez-Ortiz, H.I.; Betancourt-Galindo, R. Effects of different surface modifying agents on the cytotoxic and antimicrobial properties of zno nanoparticles. Toxicology 2016, 37, 134–141. [Google Scholar] [CrossRef]
- Menazea, A.; Awwad, N.S. Antibacterial activity of tio2 doped zno composite synthesized via laser ablation route for antimicrobial application. J. Mater. Res. Technol. 2020, 9, 9434–9441. [Google Scholar] [CrossRef]
- Liu, T.; Choi, K.-f.; Li, Y. Wicking in twisted yarns. J. Colloid Interface Sci. 2008, 318, 134–139. [Google Scholar] [CrossRef] [PubMed]
- Yu, Z.-C.; Zhang, J.-F.; Lou, C.-W.; Lin, J.-H. Wicking behavior and antibacterial properties of multifunctional knitted fabrics made from metal commingled yarns. J. Text. Inst. 2015, 106, 862–871. [Google Scholar] [CrossRef]
- Zhu, J.; Tang, T.; Hu, C.-Y.; Xiang, W.-C.; Chen, Z.-Q.; Luo, L.; Yang, H.-S.; Liu, H.-P. Cellulose nanocrystal assisted trace silver nitrate to synthesize green silver nanocomposites with antibacterial activity. RSC Adv. 2021, 11, 3808–3815. [Google Scholar] [CrossRef]
- Liu, J.; Liu, C.; Liu, Y.; Chen, M.; Hu, Y.; Yang, Z. Study on the grafting of chitosan–gelatin microcapsules onto cotton fabrics and its antibacterial effect. Colloids Surf. B Biointerfaces 2013, 109, 103–108. [Google Scholar] [CrossRef]
- Huang, C.-L.; Lee, K.-M.; Liu, Z.-X.; Lai, R.-Y.; Chen, C.-K.; Chen, W.-C.; Hsu, J.-F. Antimicrobial activity of electrospun polyvinyl alcohol nanofibers filled with poly [2-(tert-butylaminoethyl) methacrylate]-grafted graphene oxide nanosheets. Polymers 2020, 12, 1449. [Google Scholar] [CrossRef]
- Lou, C.-W.; Wu, Z.-H.; Lee, M.-C.; Lin, J.-H. Highly efficient antimicrobial electrospun pvp/cs/phmgh nanofibers membrane: Preparation, antimicrobial activity and in vitro evaluations. Res. Chem. Intermed. 2018, 44, 4957–4970. [Google Scholar] [CrossRef]
- Kamalha, E.; Zeng, Y.; Mwasiagi, J.I.; Kyatuheire, S. The comfort dimension; a review of perception in clothing. J. Sens. Stud. 2013, 28, 423–444. [Google Scholar] [CrossRef]
- Majumdar, A.; Mukhopadhyay, S.; Yadav, R. Thermal properties of knitted fabrics made from cotton and regenerated bamboo cellulosic fibres. Int. J. Therm. Sci. 2010, 49, 2042–2048. [Google Scholar] [CrossRef]
- Türkoğlu, G.C.; Sarıışık, A.M.; Karavana, S.Y. Development of textile-based sodium alginate and chitosan hydrogel dressings. Int. J. Polym. Mater. Polym. Biomater. 2020, 1–10. [Google Scholar] [CrossRef]
- Daanen, H. Physiological strain and comfort in sports clothing. In Textiles for Sportswear; Elsevier: Amsterdam, The Netherlands, 2015; pp. 153–168. [Google Scholar]
- Sheng, J.; Zhang, M.; Xu, Y.; Yu, J.; Ding, B. Tailoring water-resistant and breathable performance of polyacrylonitrile nanofibrous membranes modified by polydimethylsiloxane. ACS Appl. Mater. Interfaces 2016, 8, 27218–27226. [Google Scholar] [CrossRef] [PubMed]
- Yu, Z.-C.; Zhang, J.-F.; Lou, C.W.; He, H.-L.; Chen, A.-P.; Lin, J.-H. Wicking behavior and dynamic elastic recovery properties of multifunction elastic warp-knitted fabrics. Text. Res. J. 2015, 85, 1486–1496. [Google Scholar] [CrossRef]
- Lin, J.-H.; He, C.-H.; Huang, Y.-T.; Lou, C.-W. Functional elastic knits made of bamboo charcoal and quick-dry yarns: Manufacturing techniques and property evaluations. Appl. Sci. 2017, 7, 1287. [Google Scholar] [CrossRef] [Green Version]
- Xu, G.; Wang, F. Prediction of the permeability of woven fabrics. J. Ind. Text. 2005, 34, 243–254. [Google Scholar] [CrossRef]
- Van Amber, R.R.; Wilson, C.A.; Laing, R.M.; Lowe, B.J.; Niven, B.E. Thermal and moisture transfer properties of sock fabrics differing in fiber type, yarn, and fabric structure. Text. Res. J. 2015, 85, 1269–1280. [Google Scholar] [CrossRef]
- Yamamoto, O. Influence of particle size on the antibacterial activity of zinc oxide. Int. J. Inorg. Mater. 2001, 3, 643–646. [Google Scholar] [CrossRef]
- Aal, N.A.; Al-Hazmi, F.; Al-Ghamdi, A.A.; Al-Ghamdi, A.A.; El-Tantawy, F.; Yakuphanoglu, F. Novel rapid synthesis of zinc oxide nanotubes via hydrothermal technique and antibacterial properties. Spectrochim. Acta Part A Mol. Biomol. Spectrosc. 2015, 135, 871–877. [Google Scholar] [CrossRef] [PubMed]
- Meena, R.K.; Chouhan, N. Zno nanoparticles synthesized by a novel approach at room temperature and antibacterial activity. Science 2015, 56, 68–72. [Google Scholar]
- Alswat, A.A.; Ahmad, M.B.; Saleh, T.A.; Hussein, M.Z.B.; Ibrahim, N.A. Effect of zinc oxide amounts on the properties and antibacterial activities of zeolite/zinc oxide nanocomposite. Mater. Sci. Eng. C 2016, 68, 505–511. [Google Scholar] [CrossRef]
- Li, T.-T.; Li, J.; Zhang, Y.; Huo, J.-L.; Liu, S.; Shiu, B.-C.; Lin, J.-H.; Lou, C.-W. A study on artemisia argyi oil/sodium alginate/pva nanofibrous membranes: Micro-structure, breathability, moisture permeability, and antibacterial efficacy. J. Mater. Res. Technol. 2020, 9, 13450–13458. [Google Scholar] [CrossRef]

| Zinc Ion Yarn (Counts) | Sample Code | Twist Coefficient | cN/Tex | Irregularity (CV%) | Hairiness (H) |
|---|---|---|---|---|---|
| 2Zn-0C | 0 | 1.26 ± 0.09 | 7.33 | 365 | |
| 2 | 2Zn-1C | 1 | 1.37 ± 0.09 | 6.71 | 158.4 |
| 2Zn-2C | 2 | 1.62 ± 0.09 | 5.61 | 65.6 | |
| 2Zn-3C | 3 | 1.65 ± 0.07 | 4.42 | 20.2 | |
| 2Zn-4C | 4 | 1.55 ± 0.05 | 3.39 | 17.6 | |
| 2Zn-5C | 5 | 1.50 ± 0.12 | 8.14 | 6.8 | |
| 3Zn-0C | 0 | 1.31 ± 0.07 | 5.76 | 501.4 | |
| 3 | 3Zn-1C | 1 | 1.49 ± 0.02 | 1.80 | 281.8 |
| 3Zn-2C | 2 | 1.64 ± 0.04 | 2.29 | 39.8 | |
| 3Zn-3C | 3 | 1.67 ± 0.07 | 4.23 | 12 | |
| 3Zn-4C | 4 | 1.64 ± 0.10 | 6.60 | 6.4 | |
| 3Zn-5C | 5 | 1.62 ± 0.04 | 2.44 | 4.8 |
| Sample Code | Weight of Knitted Fabrics (g/m2) | Thickness (mm) | Tensile Stress (N) | Tensile Stress along the Weft Direction (N) |
|---|---|---|---|---|
| 2Zn-0C-K | 241.93 ± 8.72 | 0.52 ± 0.01 | 37.48 ± 8.24 | 41.71 ± 9.58 |
| 2Zn-1C-K | 257.88 ± 12.38 | 0.50 ± 0.01 | 50.46 ± 10.22 | 45.03 ± 5.91 |
| 2Zn-2C-K | 272.08 ± 9.85 | 0.50 ± 0.01 | 77.95 ± 12.28 | 51.72 ± 6.33 |
| 2Zn-3C-K | 286.15 ± 8.86 | 0.50 ± 0.02 | 83.08 ± 9.15 | 53.13 ± 6.05 |
| 2Zn-4C-K | 300.96 ± 10.50 | 0.53 ± 0.01 | 68.42 ± 10.33 | 54.76 ± 7.61 |
| 2Zn-5C-K | 319.29 ± 6.43 | 0.54 ± 0.02 | 55.19 ± 21.28 | 48.32 ± 4.61 |
| 3Zn-0C-K | 320.91 ± 5.44 | 0.73 ± 0.01 | 116.28 ± 13.69 | 79.79 ± 5.19 |
| 3Zn-1C-K | 332.79 ± 10.50 | 0.69 ± 0.01 | 129.27 ± 14.33 | 82.81 ± 7.87 |
| 3Zn-2C-K | 343.46 ± 11.85 | 0.70 ± 0.02 | 134.21 ± 15.56 | 90.07 ± 10.1 |
| 3Zn-3C-K | 352.15 ± 9.24 | 0.70 ± 0.02 | 147.50 ± 18.12 | 97.07 ± 7.26 |
| 3Zn-4C-K | 366.74 ± 5.02 | 0.75 ± 0.01 | 116.85 ± 13.71 | 88.29 ± 15.04 |
| 3Zn-5C-K | 374.82 ± 5.48 | 0.74 ± 0.02 | 84.44 ± 7.74 | 81.2 ± 9.74 |
Publisher’s Note: MDPI stays neutral with regard to jurisdictional claims in published maps and institutional affiliations. |
© 2021 by the authors. Licensee MDPI, Basel, Switzerland. This article is an open access article distributed under the terms and conditions of the Creative Commons Attribution (CC BY) license (https://creativecommons.org/licenses/by/4.0/).
Share and Cite
Lou, C.-W.; Hsieh, M.-C.; Lai, M.-F.; Lee, M.-C.; Lin, J.-H. Functional Antibacterial Nanometer Zinc Ion Yarns: Manufacturing Technique and Antimicrobial Efficacy against Escherichia coli. Appl. Sci. 2021, 11, 5021. https://doi.org/10.3390/app11115021
Lou C-W, Hsieh M-C, Lai M-F, Lee M-C, Lin J-H. Functional Antibacterial Nanometer Zinc Ion Yarns: Manufacturing Technique and Antimicrobial Efficacy against Escherichia coli. Applied Sciences. 2021; 11(11):5021. https://doi.org/10.3390/app11115021
Chicago/Turabian StyleLou, Ching-Wen, Ming-Chun Hsieh, Mei-Feng Lai, Mong-Chuan Lee, and Jia-Horng Lin. 2021. "Functional Antibacterial Nanometer Zinc Ion Yarns: Manufacturing Technique and Antimicrobial Efficacy against Escherichia coli" Applied Sciences 11, no. 11: 5021. https://doi.org/10.3390/app11115021
APA StyleLou, C.-W., Hsieh, M.-C., Lai, M.-F., Lee, M.-C., & Lin, J.-H. (2021). Functional Antibacterial Nanometer Zinc Ion Yarns: Manufacturing Technique and Antimicrobial Efficacy against Escherichia coli. Applied Sciences, 11(11), 5021. https://doi.org/10.3390/app11115021








